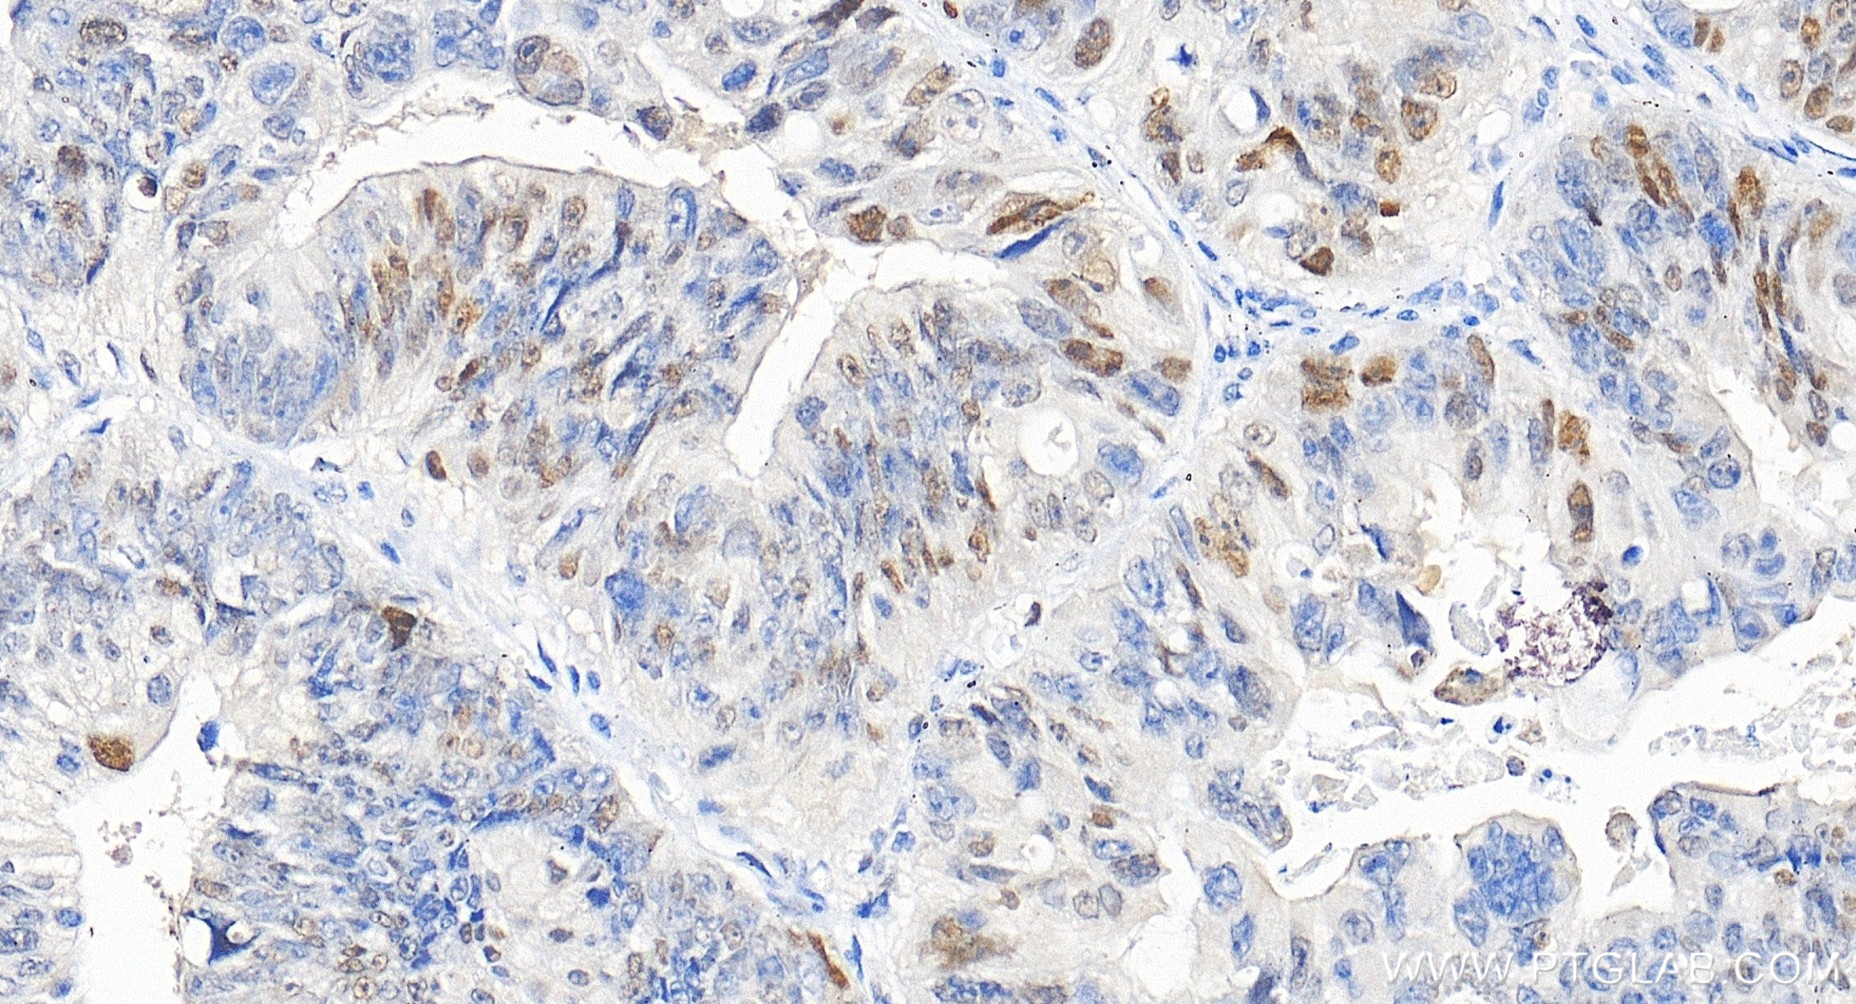
Immunohistochemistry (IHC) staining of human colon cancer tissue using P21 Recombinant monoclonal antibody (82669-2-RR)

Tested Applications
| Positive WB detected in | A549 cells, MCF-7 cells, HCT 116 cells, HUVEC cells, HeLa cells, HepG2 cells, THP-1 cells, U-87 MG cells |
| Positive IP detected in | MCF-7 cells |
| Positive IHC detected in | human cervical cancer tissue, human colon cancer tissue, human tonsillitis tissue Note: suggested antigen retrieval with TE buffer pH 9.0; (*) Alternatively, antigen retrieval may be performed with citrate buffer pH 6.0 |
| Positive IF/ICC detected in | MCF-7 cells |
Recommended dilution
| Application | Dilution |
|---|---|
| Western Blot (WB) | WB : 1:500-1:3000 |
| Immunoprecipitation (IP) | IP : 0.5-4.0 ug for 1.0-3.0 mg of total protein lysate |
| Immunohistochemistry (IHC) | IHC : 1:200-1:800 |
| Immunofluorescence (IF)/ICC | IF/ICC : 1:1000-1:4000 |
| It is recommended that this reagent should be titrated in each testing system to obtain optimal results. | |
| Sample-dependent, Check data in validation data gallery. | |
Published Applications
| WB | See 3 publications below |
Product Information
82669-2-RR targets P21 in WB, IHC, IF/ICC, IP, ELISA applications and shows reactivity with human samples.
| Tested Reactivity | human |
| Cited Reactivity | human |
| Host / Isotype | Rabbit / IgG |
| Class | Recombinant |
| Type | Antibody |
| Immunogen |
CatNo: Ag0368 Product name: Recombinant human P21;CDKN1A protein Source: e coli.-derived, PGEX-4T Tag: GST Domain: 1-149 aa of BC000275 Sequence: MSEPAGDVRQNPCGSKACRRLFGPVDSEQLSRDCDALMAGCIQEARERWNFDFVTETPLEGDFAWERVRGLGLPKLYLPTGPRRGRDELGGGRRPGTSPALLQGTAEEDHVDLSLSCTLVPRSGEQAEGSPGGPGDSQGRKRRQTSMTD Predict reactive species |
| Full Name | cyclin-dependent kinase inhibitor 1A (p21, Cip1) |
| Calculated Molecular Weight | 18 kDa |
| Observed Molecular Weight | 21 kDa |
| GenBank Accession Number | BC000275 |
| Gene Symbol | p21 |
| Gene ID (NCBI) | 1026 |
| RRID | AB_3086498 |
| Conjugate | Unconjugated |
| Form | Liquid |
| Purification Method | Protein A purification |
| UNIPROT ID | P38936 |
| Storage Buffer | PBS with 0.02% sodium azide and 50% glycerol, pH 7.3. |
| Storage Conditions | Store at -20°C. Stable for one year after shipment. Aliquoting is unnecessary for -20oC storage. 20ul sizes contain 0.1% BSA. |
Background Information
CDKN1A (p21, CIP1, WAF1) is a cyclin-dependent kinase inhibitor. CDKN1A binds to and inhibits the activity of cyclin-CDK2 or -CDK4 complexes, and thus functions as a regulator of cell cycle progression at the G1 phase. The expression of CDKN1A is induced by wild-type but not mutant p53 protein, through which CDKN1A mediates the p53-dependent cell cycle G1 phase arrest in response to a variety of stress stimuli. CDKN1A can interact with proliferating cell nuclear antigen (PCNA), and plays a regulatory role in S phase DNA replication and DNA damage repair. CDKN1A was reported to be specifically cleaved by CASP3-like caspases, which thus leads to a dramatic activation of CDK2, and may be instrumental in the execution of apoptosis following caspase activation. Two alternatively spliced variants, which encode an identical protein, have been reported.
Protocols
| Product Specific Protocols | |
|---|---|
| IF protocol for P21 antibody 82669-2-RR | Download protocol |
| IHC protocol for P21 antibody 82669-2-RR | Download protocol |
| IP protocol for P21 antibody 82669-2-RR | Download protocol |
| WB protocol for P21 antibody 82669-2-RR | Download protocol |
| Standard Protocols | |
|---|---|
| Click here to view our Standard Protocols |
Publications
| Species | Application | Title |
|---|---|---|
J Biol Chem The P53-P21-RB1 pathway promotes BRD4 degradation in liver cancer through USP1 | ||
Biochem Pharmacol IRF8 and RUNX1 cooperatively regulate the senescence and damage of urine-derived renal progenitor cells by upregulating LINC01806 |